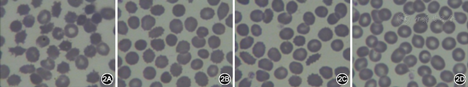

版权归中华医学会所有。
未经授权,不得转载、摘编本刊文章,不得使用本刊的版式设计。
除非特别声明,本刊刊出的所有文章不代表中华医学会和本刊编委会的观点。
患者女,23岁,未婚,汉族。以"渐进性口唇不自主咂动、咬舌、行走不稳2年余,伴肢体抽搐2次"于2014年11月27日收住院。患者入院前2年(2012年7月)开始出现口唇不自主咂动,舌不自主多动,咬舌,吐舌,伴舌体、口腔溃疡,唾液、水吞咽障碍,饮水饮食均有呛咳,流涎,发音、进食受影响,精神紧张时上述症状可加重,无头晕头痛,睡觉时口唇不自主咂动、咬舌等症状消失,家人认为是不良生活习惯,未就医。2013年10月,上述症状加重,逐渐出现双下肢力弱感,步态不稳,行走易向侧方倾倒,并出现类似跳舞样欠协调动作(曾有人诉患者走路步态如跳舞一样),时有下肢不自主抽动,上述症状均无明显波动,无晨轻暮重现象。患者至当地医院诊治,诊断为肌张力障碍,给予口服中药及针灸治疗,症状无改善。2013年12月与2014年11月25日,患者出现2次肢体抽搐,口吐白沫,双目上视,不省人事,持续2~5 min后缓解。发病后患者无发热畏寒,无咳嗽咳痰,无腹痛腹胀,睡眠正常,大小便正常。既往史、过敏史、个人史、月经史无特殊可记载,未婚。家族史:其父母否认近亲结婚,家族中无类似疾病者,其姐姐有单纯眼肌型重症肌无力病史。
入院体检:对答切题,查体合作,营养中等,自动体位,舌体前部多处咬伤,继发性溃疡,左侧第2磨牙处口咽壁可见1个绿豆大小溃疡,咽部无充血,扁桃体不肿大,心肺腹部检查无异常,脊柱、四肢无畸形。神经系统体检:神清,言语不利,构音障碍,言语讷吃,智力正常[简易精神状态检查量表(MMSE)得分29分],口唇咂动、舌体咬伤频繁,为避免咬舌和舌体不自足活动,患者口腔中放置一团毛巾,眼动充分,双瞳孔等大等圆,直径3 mm,对光反射存在,无眼震、复视,双侧鼻纹对称,伸舌居中,悬雍垂居中,双侧软腭上抬无力,咽反射明显减弱,四肢肌力Ⅴ–级,四肢肌张力减低,面部、躯干、四肢浅感觉正常,音叉振动觉正常,腱反射明显减弱,病理反射未引出,行走协调性差,颈软无抵抗,脑膜刺激征阴性,共济运动协调。辅助检查:血、粪、尿常规正常;血生化检查:电解质、血糖、尿酸、肾功能、血脂正常;ALT 48 U/L,AST 80 U/L,乳酸脱氢酶459 U/L,肌酸激酶同工酶(CK–MB)47 U/L,α–羟丁酸脱氢酶393 U/L,均升高,肌酸激酶(CK)显著升高达2 806 U/L。心功能三项:高敏肌钙蛋白T正常,肌红蛋白72.49 μg/L(升高),N末端脑钠肽原246.70 ng/L(升高)。红细胞孵育渗透脆性试验阴性。ESR、抗链球菌溶血素O、类风湿因子、C反应蛋白正常。体液免疫五项(IgG、IgA、IgM、补体C3、补体C4)正常。钩端螺旋体IgG抗体、抗髓过氧化物酶抗体、抗蛋白酶3抗体阴性。结核分枝杆菌TB–DOT试验阴性。肝病寄生虫全项(–),广州管圆线虫抗体(±),日本血吸虫IgG抗体(–)。抗–HCV、抗–HIV、HIV–Ag、梅毒螺旋体抗体阴性。甲状腺功能正常。促卵泡激素、黄体生成素、雌二醇、睾酮均正常,催乳素38.35 μg/L(升高)。肿瘤标志物、肝炎分型正常。腰椎穿刺:脑脊液压力155 mmH2O(1 mmH2O=0.009 8 kPa),无色透明,红细胞40×106/L(穿刺伤),白细胞0,潘氏试验阴性,葡萄糖3.56 mmol/L,LDH 14 U/L,蛋白900 mg/L,腺苷脱氨酶0.10 U/L,新型隐球菌涂片、脑脊液结核菌涂片均阴性,脑脊液培养未见细菌和真菌生长。X线胸片、心电图、脑电图正常。经颅多普勒示:左侧大脑前、后动脉血流速度稍增高。消化系、泌尿系、妇科B超正常。肌电图示多发性周围神经损害。眼科裂隙灯下未见角膜K–F环。头颅MRI显示双侧尾状核头部萎缩(图1)。患者第1次外周血涂片高倍镜下见棘红细胞,占红细胞计数的50%,第2次外周血涂片棘红细胞占红细胞计数25%。患者父亲(50岁)、母亲(48岁)、姐姐(27岁)外周血涂片均可见棘红细胞,分别占红细胞计数的30%、25%和2%(图2)。患者诊断为舞蹈病–棘红细胞增多症(chorea–acanthocytosis, ChAc)。

患者外周血送金域医学检验中心行ChAc相关基因测序:通过对MTTP、VPS13A、XK等基因外显子编码区进行直接测序,检测到1个杂合致病突变,VPS13A基因c.9403C>T p.(Arg3135*)杂合突变,为致病突变。
本例特点为:(1)青年女性,缓慢起病,逐渐进展;(2)口舌不自主多动,经常咬伤舌体并继发舌体口腔溃疡,流涎,言语含糊不清,行走不稳,侧向倾倒,癫痫发作,呈强直阵挛发作,咽反射减弱,肌张力减低,腱反射减弱;(3)父母非近亲结婚,家族中无类似疾病患者,父亲家系和母亲家系未见其他患病者,父母为可疑携带者,符合常染色体隐性遗传的特点;(4)乳酸脱氢酶、肌酸激酶、催乳素增高,肌电图示多发周围神经损害;(5)患者外周血涂片查到大量棘红细胞,其父母外周血均可查到多量棘红细胞;(6)颅脑MRI扫描显示尾状核萎缩;(7)检测到突变基因在VPS13A。
本病属神经系统遗传性疾病,目前无特效疗法,以对症治疗为主。入院后给予氟哌啶醇,由1 mg 2次/d逐渐增加到2 mg 3次/d,维生素E 100 mg 3次/d,复合维生素B 2片3次/d,丁苯酞2片3次/d,肌苷0.4 g 3次/d,ATP 20 mg 3次/d,辅酶Q10 10 mg 3次/d,加强口腔护理,心理安慰,吞咽、舌体功能练习。经18 d治疗后,口唇不自主咂动明显减少,吐舌不明显,流涎减少,吞咽仍存在少许障碍,时有饮水呛咳,仍舌体咬伤,有舌体、口腔溃疡,行走不稳感明显改善,无肢体倾倒感。门诊追踪病情变化,症状一度稳定,口唇咂动改善,可以自主进食,流涎症状改善。2015年5月,因费用因素停用丁苯酞,6月加用苯海索(2 mg 3次/d)改善肌张力障碍。目前患者可自主进食,偶有口舌咬伤,行走时有不稳感,但没有发生过倾倒,生活自理,恢复轻工作。
ChAc为罕见的神经变性常染色体隐性遗传病,临床以渐进性神经退行性变、进行性口舌不自主运动、自残性唇舌咬伤、舞蹈样动作、构音障碍、癫痫、周围神经损害及棘红细胞增多为其特征性改变。ChAc为神经棘红细胞增多症的一种亚型。最早于1960年由Levine等[1]和Critchley等[2]首先报道,国内最早于1984年由杨任民等[3]首先报道。ChAc国内外发病情况类似,均属于罕见神经系统遗传性疾病。
ChAc的临床特征以锥体外系症状、体征及血液学、神经影像改变的特点为主[4,5,6,7]:(1)发病年龄8~62岁,平均32岁,男多于女;(2)以舌肌、口唇和咀嚼肌的不自主运动为特征,吐舌,进食性肌张力障碍,常伴肢体或躯干的舞蹈样动作、咬舌、咬唇;(3)癫痫、认知障碍和精神异常;(4)肌张力减低,腱反射减弱或消失,肌电图示周围神经损害;(5)涉及多系统;(6)外周血棘红细胞增多(占5%~50%,需除外肝脏疾病、脾切除术和溶血性贫血);(7)血清肌酸激酶增高;(8)CT或MRI示侧脑室前角增宽,尾状核萎缩。
尽管本例患者出现大量的棘红细胞,但患者未出现贫血及低氧血症,无凝血机制障碍及脂代谢紊乱。本例患者血催乳素增高,在ChAc中少见,国内已有ChAc催乳素增高的报道[8],推测与下丘脑–垂体–多巴胺能系统的激素分泌调节功能受损有关。
由于ChAc致病基因众多,突变位点多样,没有明确病变外显子,遗传学基础复杂,目前国内未建立有效的基因诊断方法,国内所有报道病例均为临床诊断[9]。本例患者进行了ChAc的基因突变测序,发现了突变基因,为VPS13A c.9403C>T p.(Arg3135*)杂合致病突变,该突变为无义突变(预计会使所编码蛋白质第3 135位氨基酸由精氨酸变为终止密码子),可使蛋白翻译提前终止,为本病的致病突变。文献报道,在ChAc合并肥厚型/扩张型心肌病患者中检测到该突变[10,11]。本例检测到的基因突变符合ChAc常见突变类型。
目前ChAc无特效药物治疗,安坦、溴隐亭、安定、氯硝西泮、抗5–羟色胺剂等对不自主运动无效[12]。大剂量维生素E(5 000~10 000 mg/d)可以改变红细胞膜的流动性,部分患者有改善。抗多巴胺能药物氟哌啶醇可缓解症状。深部脑刺激技术(DBS)作用于丘脑腹眶侧部(Vop),对躯干痉挛有改善作用[13]。
该病的护理非常重要[14,15],加强口腔护理,保持放在口腔里的手绢清洁卫生,选择高蛋白、高维生素、高热量、易消化食物,少量多餐,如进食困难出现营养障碍,应进行鼻饲改善其营养状况。此外,加强吞咽训练,改善吞咽功能,促进整体康复,进行心理疏导,缓解抑郁焦虑情绪,树立信心。





















